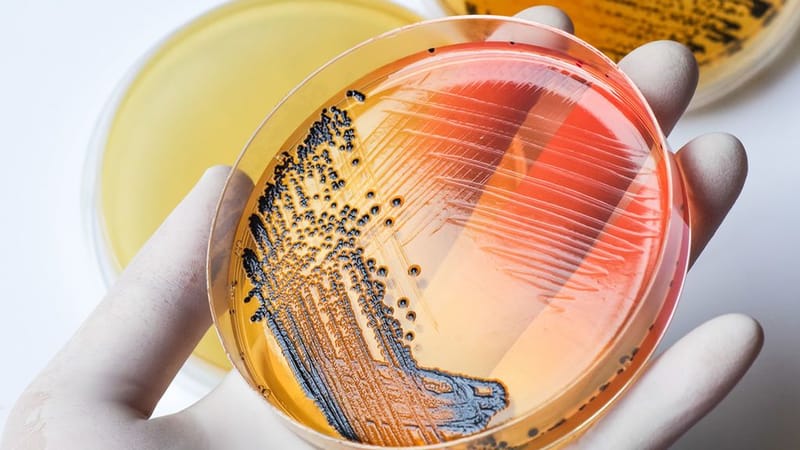
الاحياء الدقيقة والطفيليات

يُعَد قسم الكيمياء الحيوية والهرمونات من الأقسام الرئيسية في مختبرات لابتك التخصصية، حيث يُقدّم مجموعة واسعة من الفحوصات المخبرية تشمل تقييم وظائف الأعضاء، مؤشرات الأمراض المزمنة، ومستويات الهرمونات المختلفة. يعتمد القسم على أجهزة أوتوماتيكية متطورة وتقنيات حديثة تضمن أعلى درجات الدقة والموثوقية، بإشراف كادر متخصص يحرص على سرعة إنجاز النتائج لدعم التشخيص الطبي وخطط العلاج.
يختص قسم أمراض الدم والمناعة في مختبرات لابتك التخصصية بإجراء الفحوصات المرتبطة بتشخيص اضطرابات الدم مثل فقر الدم وأمراض النزف والتجلط، إضافة إلى اختبارات وظائف الجهاز المناعي وتشخيص أمراض المناعة الذاتية والحساسية. يعتمد القسم على أجهزة دقيقة وتقنيات متقدمة، ويشرف عليه فريق متخصص يضمن دقة وسرعة النتائج لدعم القرارات الطبية السليمة.
يُعنى قسم الأحياء الدقيقة والطفيليات في مختبرات لابتك التخصصية بالكشف عن مسببات العدوى البكتيرية والفطرية والطفيلية، وذلك من خلال أحدث التقنيات المخبرية والأجهزة الأوتوماتيكية المتقدمة. كما يوفّر القسم اختبارات زراعة وعزل وتشخيص دقيقة، تسهم في تحديد العلاج المناسب ودعم الأطباء في إدارة الحالات المرضية المرتبطة بالعدوى.
يُعد قسم فحوصات الوراثة والأحياء الجزيئية في مختبرات لابتك التخصصية من الأقسام المتقدمة، حيث يُعنى بالكشف عن الاضطرابات الوراثية والأمراض الجينية باستخدام أحدث تقنيات التشخيص الجزيئي مثل تفاعل البلمرة المتسلسل (PCR) وتقنيات الكشف الجيني المتطورة. يساهم هذا القسم في تشخيص دقيق وشامل يساعد الأطباء في وضع خطط علاجية فعّالة، ويعزز من القدرة على الكشف المبكر عن الأمراض الوراثية والمعدية.
يُعنى قسم فحوصات المياه والأغذية في مختبرات لابتك التخصصية بضمان سلامة وجودة المنتجات الغذائية ومصادر المياه، من خلال إجراء اختبارات كيميائية وميكروبيولوجية متقدمة وفق أعلى المعايير الدولية. يتمتع القسم باعتماد ISO 17025 الذي يؤكد كفاءته الفنية ودقة نتائجه، مما يجعله مرجعًا موثوقًا للهيئات الصحية والمؤسسات والشركات في مجال الرقابة على جودة المياه والأغذية.